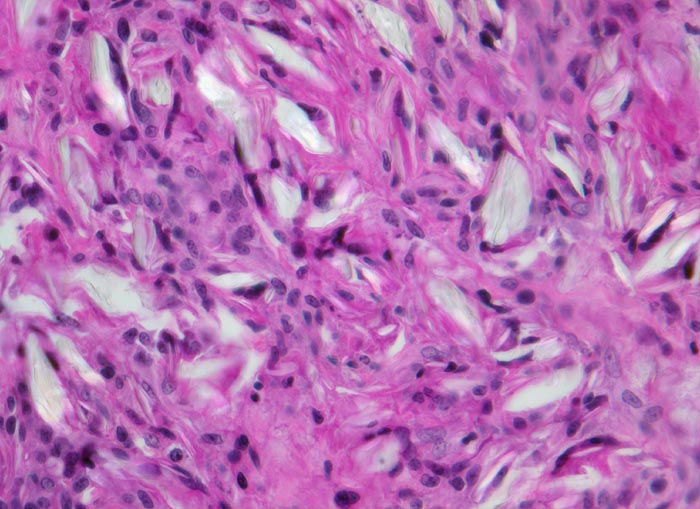

PathoPic – image database / PathoPic ID 4657 - Fremdkörpergranulom
de
Diagnose
Fremdkörpergranulom
Diagnose Gruppe
Artefakt / Fremdkörper / Pigment
Topographie
Weichteile
Topographie Gruppe
Weichteile
Beschreibung
Klinik
Operationspräparat
Kommentar
Wegen fehlenden klinischen Angaben zu vorausgegangenen Operationen kann die Natur des Fremdmaterials nicht sicher angegeben werden.
Bilder Typ
Histologie
Vergrösserung
320
Alter
63
Geschlecht
unbekannt
Datum
Ersteintrag: 06.10.2002
Update: 04.02.2024